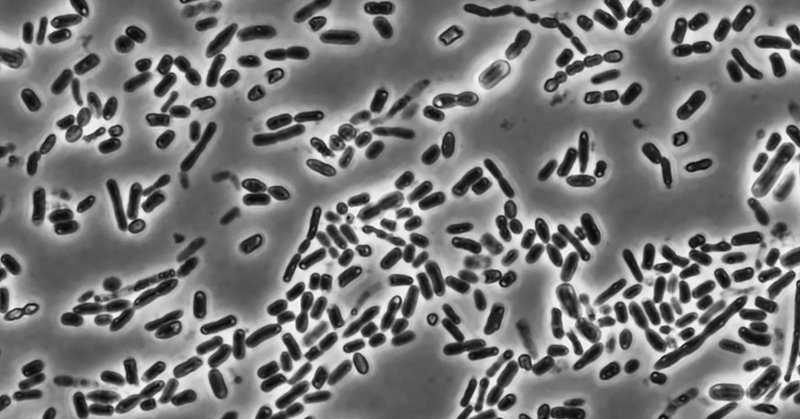
Tweet card summary image

Nathalie Bechon
@nath_bechon
Followers
208
Following
128
Media
9
Statuses
300
Post-doc @SorekLab @WeizmannScience on bacterial immune system. Bacteria stick together, why can't we?
Joined October 2021
It has been a journey and here it is: my first post doc paper is out in Nature Communications 🎉🎉🎉 If you red the preprint, it's worth checking the revised manuscript, we added some cool stuff. A thread. ⬇️ https://t.co/TrG3ku8NQU
nature.com
Nature Communications - Avs proteins are bacterial anti-phage pattern recognition receptors evolutionarily related to eukaryotic NLRs. Here, Béchon et al show that a single bacterial Avs can...
7
30
129
A choanoflagellate cGLR-STING pathway reveals evolutionary links between bacterial and animal immunity https://t.co/n2Sza9NT48
#biorxiv_immuno
biorxiv.org
Animal innate immunity evolved from ancient pathways in bacterial anti-phage defense. How bacterial immune components were first acquired and adapted within eukaryotic cells remains poorly understo...
0
1
1
📢 Preprint out! Together with @reneechang and the amazing @SorekLab , we explored viral sponges to map their diversity and function. Discovered huge diversity, including sponges that inhibit Pycsar & Type IV Thoeris! https://t.co/ZhHMK7KB6O
biorxiv.org
Multiple bacterial immune systems, including CBASS, Thoeris, and Pycsar, employ signaling molecules that activate the immune response following phage infection. Phages counteract bacterial immune...
1
15
26
📣 Looking for a creative postdoc with strong computational skills! Be our go-to person for building simple but powerful simulations that test wild ideas on biological rhythms: from daily cycles of mussel groups at deep sea, to firefly flash synchronization! More info👇
2
66
132
A prosperous future is intertwined with science and innovation. And right now, our science needs rebuilding. Help us restore the heart of discovery. Support the Weizmann Institute of Science. DONATE NOW >>
48
84
341
Thrilled to share our new preprint on using a new type of microbial memory to track horizontal gene transfer in environmental microbial communities. Amazing collaboration with @ChappellLab and @JoffSilberg labs. https://t.co/bzBiCDjQin (1/n)
biorxiv.org
Biological recorders can code information in DNA, but they remain challenging to apply in complex microbial communities. To program microbiome information storage, a synthetic catalytic RNA (cat-RNA)...
2
15
51
Please repost: Postdoc position in antibiotic discovery in a multidisciplinary project w. high-throughput approaches, microscopy, AI, and hit-to-lead optimization @UMontreal @med_umontreal @Mila_Quebec @IRIC_umontreal. Apply @ ML.Antibiotics@gmail.com. See https://t.co/2DjrErxpqw
4
46
84
We are excited to report the discovery of TIGRs, a widely-occurring RNA-guided system found in bacteria and their viruses. TIGRs consist of a peculiar repeat region which is transcribed into RNA and processed into multiple guide RNAs to direct TIGR-associated proteins to their
science.org
RNA-guided systems provide remarkable versatility, enabling diverse biological functions. Through iterative structural and sequence homology-based mining starting with a guide RNA-interaction domain...
26
271
1K
It is finally out! Muntathar Al-Shimary, Doudna Lab, @bradyfcress and I present a gene knockdown tool that works in diverse phages: CRISPRi through antisense RNA Targeting (CRISPRi-ART)! Check out the final paper in @NatureMicrobiol
https://t.co/DJkBM5fhPL
nature.com
Nature Microbiology - Leveraging RNA-targeting dCas13d enables selective interference with phage protein translation and facilitates measurement of phage gene fitness at a transcriptome-wide scale.
3
47
127
So happy that I can finally share the results of my first postdoc paper with @baym!! Turns out plasmids are an amazing system to study multi-scale evolution and we can track within-cell and between-cell dynamics! Here’s a photo of plasmids competing inside cells in a colony (1/n)
12
99
519
ActSeek: Fast and accurate search algorithm of active sites in Alphafold database 1. ActSeek introduces a novel approach to searching protein databases for similar active sites using a fast algorithm inspired by computer vision, enhancing the search for proteins with specific
1
30
127
🚨 🧬 Updated preprint on the completed BASEL collection - what's new? Some fun with bacterial immunity and a new P22 relative infecting E. coli K-12. A thread 🧵
3
33
111
Prof. Martin Steinegger's team at SNU has developed Foldseek-Multimer, a rapid and highly sensitive protein complex structural aligner. This breakthrough allows for the comparison of billions of complex pairs in just 11 hours. By computing complex alignments, Foldseek-Multimer
3
65
204
Nature research paper: Limited impact of Salmonella stress and persisters on antibiotic clearance https://t.co/UuFdNNwjJ2
nature.com
Nature - Experiments in infected mice and tissue-mimicking chemostats show that resilience of Salmonella against antimicrobial compounds is largely a result of starvation-induced general resilience...
3
9
49
Now published @ScienceMagazine: TIR signaling activates caspase-like immunity in bacteria We report a new immune molecule: N7-cADPR. Produced by phage-induced TIRs and activates a defensive bacterial caspase Congrats @FrancoisRousset & @IlyaOsterman! https://t.co/cgGFIUqSLZ
3
40
158
Very happy our paper on CARD domains in gasdermin anti-phage defense systems is now published in @Nature 🥳 Thanks to all the people involved especially the Kranzusch lab and @SorekLab
https://t.co/ZnFeX8zPpY
5
37
140
🚨We are hiring! A MRC-funded PDRA position to study novel anti-phage systems & their evolutionary dynamics in P. aeruginosa, in collaboration with @friendlymicrobe. If you are passionate about phage-bacteria interactions & evolution, apply now !
1
37
73
Happy to share our latest findings on Kiwa. Foundational work from Thomas, with Zhiying and Yi providing beautiful structures and molecular insights. Ever grateful for the collaborations with Eugene and Dinshaw. More to come 🙃 https://t.co/I7du7lcBRr
1
14
51
I'm thrilled to announce our latest work is now published in Cell! Viruses encode numerous proteins that inhibit host defenses, but identifying immune-modulatory proteins among millions of viral sequences has been nearly impossible - until now! https://t.co/AeMfArapnG
3
55
258
1/14 Excited to share our new @Elinav_Lab @Elinav_DKFZ @WeizmannScience paper @CellCellPress, championed (for 6 years!) by the amazing @rvaldesmas, @AvnerLeshem, @DanpingZheng and twitter-less Alon Savidor. In this work, we’ve adopted into microbiome..
8
35
105
Our lab is recruiting postdocs with strong expertise in molecular microbiology and/or phage biology to work on different antibiotics-related projects (more info https://t.co/zkDrD2h3Aw). Please get in touch if interested (with CV and references)!
epfl.ch
UPGOEMANS
5
75
144